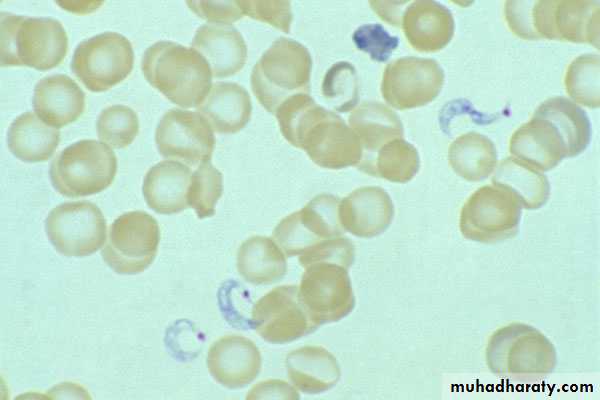
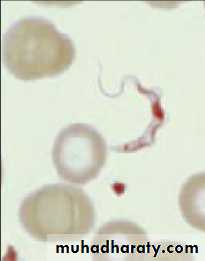

Trypanosomiasis
African TrypanosomiasisLife cycle of Trypanosoma
brucei gambiense & T. b. rhodesienseAfrican sleeping sickness
Trypanosoma brucei rhodesiense: East Africa, wild and domestic animal reservoirs
Trypanosoma brucei gambiense: West and Central Africa, mainly human infection
Tsetse fly
Pathology and clinical picture
• Skin stage: chancre.• Haematolymphatic stage: generalized lymphadenopathy, anaemia, generalized organ involvement.
• Central nervous system stage (CNS): Meningoencephalitis.
• (Development of the disease more rapid in Trypanosoma brucei rhodesiense)
chancre
Winterbottom’s stage
3rd stage CNS
Lymph node aspirate
trypanosoma
CSF
AMERICAN TRYPANOSOMIASIS
LIFE CYCLE OF Trypanosoma cruzi
Reduviid (Triatomine) bugDiagnosis
Blood filmSerology: IFAT
Xenodiagnosis: feeding bugs on a suspected cases.
T. cruzi causes cutaneous stage (chagoma)
Ocular (Romana’ sign)
C-shape
TREATMENT
African trypanosomiasisFor early infection
pentamidine
suramin
For late infection
eflornithine (Diflouromethylornithine- DFMO)
American trypanosomiasis (Chaga’s disease)
benznidazolenifurtimox
Trichomonas vaginalis
Transmission:
sexual intercoursecontact with contaminated objects.
Pathology
Female:
vaginitis, profuse thin yellowish discharge with bad smell
Male:
invasion of urethra, prostate and seminal vesicles, causing urethritis but mostly asymptomatic.trophozoites
Diagnosis
Identification of parasite by microscopy of discharge.
Examination of vaginal or urethral discharge for T. vaginalis
Treatment:
metronidazole (flagyl).Note:
Treat sexual partner because infection is mostly asymptomatic in males.TrypanosomiasisSleeping Sickness
DiagnosisDirect microscopy
Blood (T.b.r.)Lymph node aspirate (T.b.g.)
Lumbar puncture (Late T.b.r. & T.b.g.)
Serology
Animal inoculation
African trypanosomiasis
African trypanosomiasisLife cycle
Primary chancre
Tsetse fly
AMERICAN TRYPANOSOMIASIS
Reduviid (Triatomine) bug
Spread of infection by defecation of kissing bug
DiagnosisBlood film
Serology: IFAT
Xenodiagnosis: feeding bugs on a suspected cases.
T. cruzi causes cutaneous stage (chagoma
Ocular (Romana’ sign)
C-shape
Trypomastigote
Amstigotes
TREATMENT
African trypanosomiasisFor early infection
pentamidine
suramin
American trypanosomiasis (Chaga’s disease)
benznidazole
nifurtimox